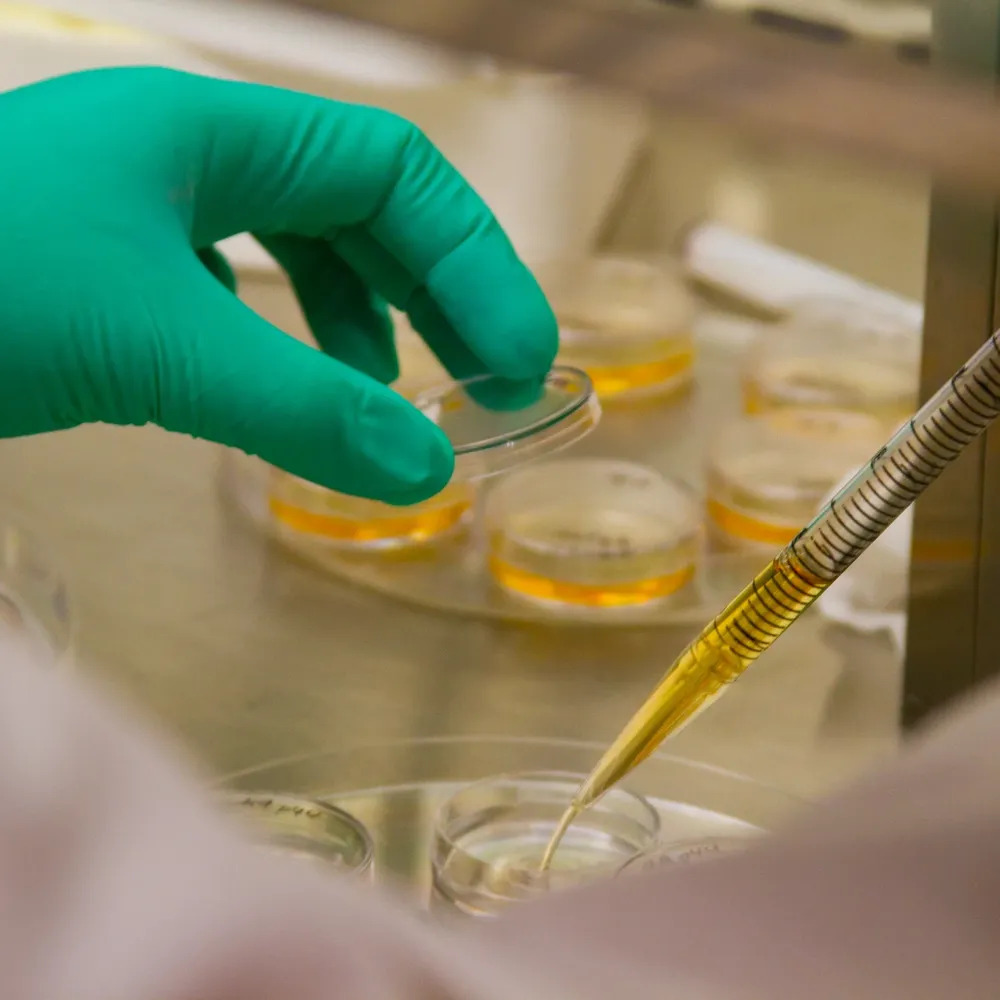
0000326747.webp

Una nueva técnica que utiliza células madre adheridas a hilos de sutura usados en cirugía, desarrollada por investigadores de la universidad brasileña de Campinas (Unicamp), puede revolucionar la medicina de regeneración de tejidos, según aseguró el lunes uno de los responsables del estudio.
Para cicatrizar más rápido
Investigadores brasileños desarrollaron una técnica inédita con células madre adheridas a hilos de sutura usados en cirugía, que podría revolucionar la medicina de regeneración de tejidos